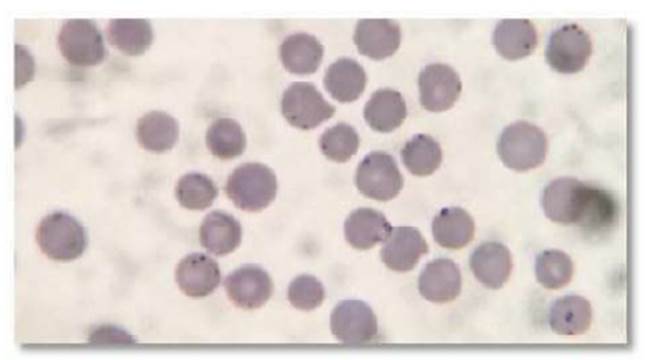

INTRODUCCIÓN
La fragmentación de los hábitats y el aumento de la proximidad entre las comunidades humanas, animales domésticos y silvestres puede facilitar la aparición de enfermedades emergentes, diseminación de patógenos y alteraciones del patrón epidemiológico de las enfermedades (Furtado, 2010). El personal encargado del manejo de especies silvestres debe ser consciente de las enfermedades emergentes en la región para minimizar el posible impacto de tales enfermedades en la población animal, tanto doméstica como silvestre, así como en los humanos (Williams et al., 2002).
Los hemoplasmas son bacterias pleomórficas responsables de una variedad de enfermedades en humanos, animales y plantas. Estas bacterias pertenecen a la familia Mycoplasmataceae y se localizan en las regiones epicelulares de los eritrocitos, sien- do el género Mycoplasma de mayor impor- tancia en medicina veterinaria (Baker et al., 1998; Biondo et al., 2009). Como en muchas otras enfermedades infecciosas, los estudios epidemiológicos sobre Mycoplasma en animales de vida silvestre son escasos.
La micoplasmosis puede afectar a un gran número de animales silvestres, entre ellos rumiantes silvestres (Arif et al., 2007; Friend, 2006), primates no humanos (Moller et al., 1978; Stipkovits, 1989, 1990; Schoeb et al., 1997), elefantes (Kirchhoff et al., 1996), reptiles; (Hill, 1985) y aves (Luttrell et al., 2001; Ley et al., 2006 1996 1998), solo por citar algunos.
Se tiene evidencia de aislamiento de micoplasmas en el mapache norteamericano (Procyon lotor) en vida libre (Volokhov et al., 2017), así como en el perro mapache ja- ponés (Nyctereutes procyonoides viverrinus) (Kanamoto et al., 1981). Los signos y síntomas están asociados con una condición clínica caracterizada por epifisitis y periostitis (Williams y Barker, 2001), siendo identificado por primera vez en mapaches silvestres en Canadá por Williams y Barker (2001).
En Sudamérica y parte de Centroamérica existe una especie del género Procyon conocido como aguará popé u osito lavador (P. cancrivorus). Según Rodrigues y Auricchio (1994), tiene una amplia distribución geográfica, encontrándose en todo el territorio neotropical desde Costa Rica y Panamá hasta Uruguay, noreste de Argentina, Brasil y Paraguay. En el territorio para- guayo, se distribuye en casi todos los depar- tamentos y ecosistemas, con excepción del departamento de Boquerón (Reid et al., 2016).
P. cancrivorus es un carnívoro silvestre, que alcanza 1 m de longitud, incluida la cola, y pesa hasta 10 kg. Su pelaje puede variar desde marrón oscuro a gris, siendo fácilmente identificado por una máscara negra que se extiende desde los ojos hasta la base de la mandíbula. La cola es larga y peluda con rayas que forman de 5 a 10 anillos oscuros, que permanece baja durante el trote. La cabeza es corta con el hocico puntiagudo, las orejas son de color negro semi redondeado con bordes blancos, y los ojos son grandes, negros, redondos y casi enteramente orientados hacia adelante (Câmara y Murta, 2003; Cubas et al., 2006; Mamede y Alho, 2006; Reis et al., 2006).
Se reporta la presencia de Mycoplasma sp en Procyon cancrivorus, siendo el primer reporte para la especie, tanto para animales en cautiverio como de vida libre, en Paraguay.
CASO CLÍNICO
El caso clínico fue reportado en el municipio de la ciudad de Asunción, departamento Central, Paraguay, ubicado a una altitud de 89 msnm, el 10 de julio de 2018. El médico veterinario fue contactado por el propietario. En un recinto de aproximadamente 2 m2 y de 2.5 m de alto se encontraban tres ejemplares de Procyon cancrivorus (dos hembras y un macho de 4-5 meses de edad).

Figura 1 Contención física de un Procyon cancrivorus y toma de muestra de sangre periférica a partir de vena marginal de la oreja
En la valoración física, el peso promedio de los tres ejemplares fue entre 4 y 6 kg, presentaban estado febril (39.5 °C), estado de letargia, inapetencia, apatía, disminución de peso, poca o nula movilidad del tren posterior que progresó en una paraplejia y con mucosas pálidas. Además, los ejemplares estaban infestados con garrapatas (Rhipicephalus spp) y pulgas (Ctenocep- halides spp). El propietario manifestó que había tenido cuatro ejemplares, pero que uno murió días antes, sin haber manifestado signos clínicos previos. A la anamnesis e inspección clínica de los ejemplares se constató la presencia de signos clínicos compatibles con micoplasmosis, erlichiosis o babesiosis.
Se procedió a la toma de sangre periférica de los ejemplares, a partir de la vena marginal de la oreja, realizando la sujeción física siguiendo el método propuesto por Torres-Chaparro y Quintero-Sánchez (2006) (Figura 1). Se hicieron frotis a partir de la muestra de sangre en láminas portaobjetos, secadas al aire, fijadas en alcohol metílico y almacenadas en contenedores a temperatura ambiente, para su envío al laboratorio de la clínica veterinaria. También se tomaron muestras de sangre a partir de la vena safena (1 ml) en tubos con anticoagulante EDTA y remitidas al laboratorio del Servicio Nacional de Sanidad y Calidad Animal (SENACSA), para el análisis del hemograma.
Las muestras de frotis sanguíneo fue- ron analizadas mediante técnicas citológicas, según el protocolo de Valenciano y Cowell (2019). Los frotis fueron coloreados con Giemsa y con Diffquick, esta última es una variante comercial de la tinción de Romanowsky (Martoja M y Martoja R, 1974). Las láminas teñidas fueron observadas en un microscopio Advanced Optical UB200i-br en aumentos de 40X y 100X. La interpretación de los resultados se realizó teniendo en como referencia las imágenes publicadas por Weiss y Wardrop (2010) y Reagan et al. (2019) y consultas con expertos en el área.
RESULTADOS
El diagnóstico citológico fue positivo para micoplasmosis en los tres individuos. Se observaron estructuras de 8 µm compatibles con Mycoplasma sp, sin pared celular, de forma redondeada (cocos), en bastones ani- llos que se adhieren a la pared de los eritrocitos (Figura 2), dacriocitos (hematíes en forma de lágrima) y trombocitosis (formando agrega- dos en algunos casos). Lastimosamente no se pudo llegar al resultado del hemograma, porque la muestra se dañó durante el traslado al laboratorio. No se tomaron muestras adicionales por decisión de los técnicos para no estresar a los animales en una segunda captura y colecta y por la negación de los propietarios, luego de ver mejoría en los animales.
Figura 2 Microscopía de frotis sanguíneo de Procyon cancrivorus. Se observan estructuras de 8 µm compatibles con Mycoplasma sp, sin pared celular, de forma redonda, dentro de los eritrocitos
Los animales fueron tratados con enrofloxacina (10 mg/kg) cada 48 h por dos semanas (Carpenter, 2018), mostrando una rápida y pronta mejoría, tal y como se observa en la Figura 3, tomada 15 días después del inicio del tratamiento. Al término del trata- miento se tomaron muestras de sangre y no se encontraron estructuras compatibles con Mycoplasma sp en los frotis.
DISCUSIÓN
El contacto social puede ser considera- do una forma de transmisión de micoplasmas, sea por interacciones agresivas (peleas) o por contacto con sangre de animales infectados (por medio de mordidas) (Museux et al., 2009). Asimismo, las garrapatas del género Rhipicephalus y pulgas del género Ctenocephalides son capaces de transmitir cierto tipo de Mycoplasma (Alves et al., 2014), de allí que la presencia de estos ectoparásitos en los animales estudiados pudo ser un factor de riesgo para el contagio entre ellos.
Los micoplasmas hemotrópicos son agentes causante de anemia infecciosa en una gran variedad de especies de mamíferos (Willi et al., 2007) lo que puede ser causante de las mucosas pálidas de los animales aten- didos, y si bien no se pudo tener los resulta- dos del hemograma, pudo haber sido la cau- sa de la muerte del animal que no fue atendido. Según Messick (2003), la anorexia, letargo, pérdida de peso y fiebre pueden indicar una mayor gravedad y llevar al animal a la muerte.
El diagnóstico realizado por microscopía de frotis sanguíneo no es el método más indicado para el diagnóstico de micoplasmosis, pues no es posible llegar a la especie (Tasker y Lappin, 2002). El PCR es considerado el método de diagnóstico definitivo para la detección e identificación de la especie patógena (Santos, 2008).
En este sentido, Volokhov et al. (2017) en Georgia, USA, reportaron Mycoplasma hemotropico en mapaches (Procyon lotor) de hábitats urbanos y no perturbados, a partir de PCR, y Volokhov et al. (2020) hallaron Mycoplasma sp, cepa LR5794, en la cavidad oral de un mapache a partir de cultivo bacteriano. En Brasil, Cubilla et al. (2017) y de Souza et al. (2017), a partir de PCR, detectaron Mycoplasma haemofelis y Mycoplasma sp en coatí (Nasua nasua) en cautiverio, y en mamíferos silvestres, respectivamente.
Pese a que varios autores recomiendan el tratamiento con doxiciclina (Pérez e Iglesias, 2007), amoxicilina + ácido clavulánico (Willi et al., 2010) y oxitetraciclina (Molina y Pacheco, 2016), la enrofloxacina demostró tener efecto positivo y lograr una rápida mejoría en los tres pacientes. Shaw (2003) recomienda el tratamiento con enrofloxacina (5- 10 mg/kg) oral por 3-4 semanas en gatos con anemia clínica. En el presente estudio, el tratamiento realizado por dos semanas fue suficiente para reducir las señales clínicas y dar negativo en el examen diagnóstico.
CONCLUSIONES
Se reporta el caso de micoplasmosis en Procyon cancrivorus, el cual, de acuerdo con el conocimiento de los autores, podría considerarse el primer reporte de este hemoplasma en la especie en Para- guay.
El tratamiento con enrofloxacina a una dosis de 10 mg/kg por dos semanas a intervalos de 48 h demostró ser un trata- miento efectico para esta patología.












 uBio
uBio 


